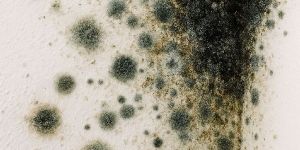
mold fungus treatment service

Get Price Quote

495 / Piece

520 - 600 / Bottle

Get Price Quote

Get Price Quote
Get Price Quote